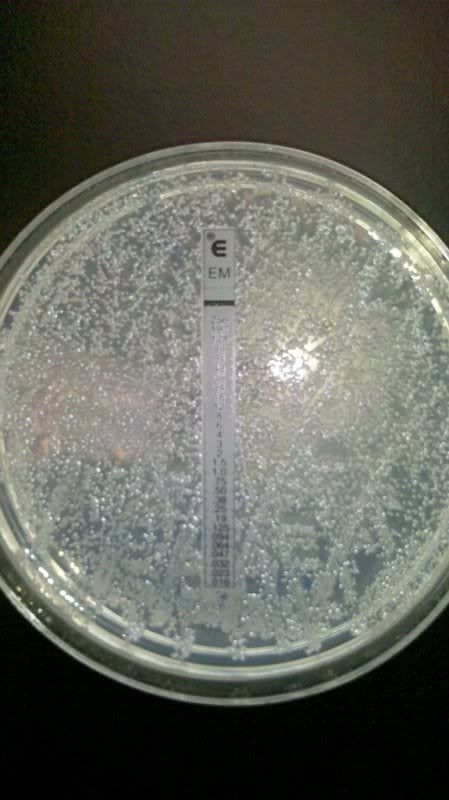
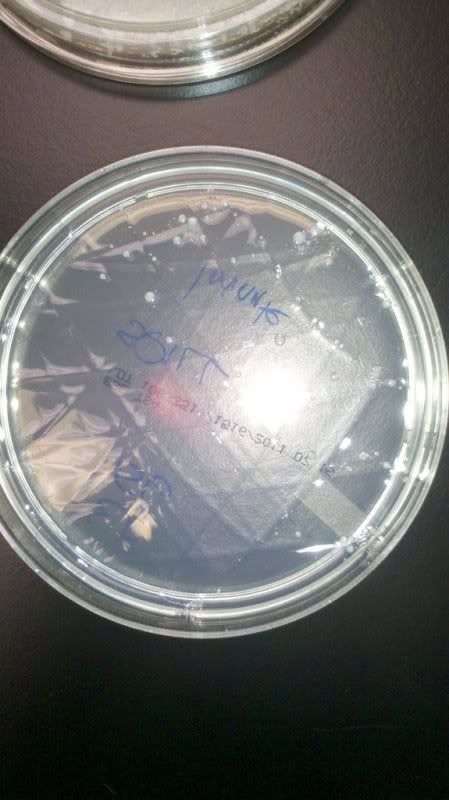
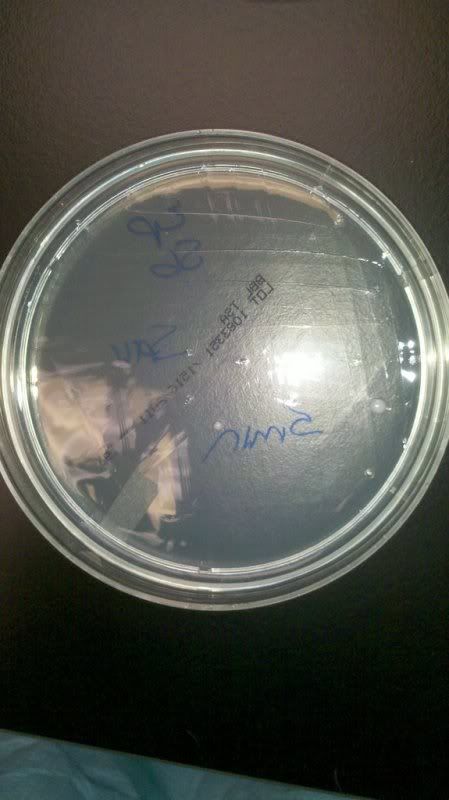
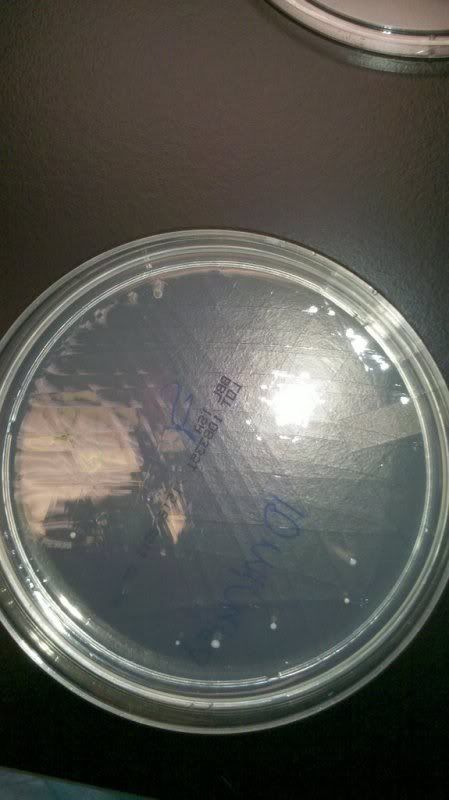

Moving, Yard sales, and Sweet Success...
The anticipation is killing me...
Two more weeks and i'll be living in good ol' Portsmouth, NH which I think is the most beautiful city in New Hampshire.
The Apartment is two floors, two bedrooms and 1.5 bathrooms. Has a big deck and backyard, attic, basement, and is 5 min from downtown, and 10 minutes from the beach. Pictures to come.
The woman who is moving out of the place we're moving into had a yard sale. I won't lie, she had some nice things from pottery barn, and we did get some pretty ridiculous deals. Mike and I are helping her move. But Mike did score this picture from pottery barn that she was trying to sell for $50 FREE.

This is a pretty large picture. But I love these beachy images.

I think this will definitely help with nursing school and when I want to go to NP or ND school. And its handy just to have on hand for a sinus infection. How much did I pay? Nada.

This Ionizing fan was originally $50. Got it for $10.

Then you always need your flour and sugar jars. I think these were $5 all together.
Oh, and we got a grill and patio set for $150! :)
Oh, and we got a grill and patio set for $150! :)
So in two weeks I'll be out of manchghanistan and finished summer classes. I'm maintaining A's in both Microbiology and Statistics.
Microbiology is fascinating. We were learning about how antibiotics work against bacteria. Here are some of the experiments we did.
This is called the E test and if the bacteria were susceptible there would have been a zone(circle) of no growth at a certain number. But this bacteria is resistant because it's called Candida albicans which is a yeast (responsible for yeast infections, etc) and eukaryotic, and antibiotics are ineffective against yeast. You need an anti-fungal.

This is the same organism with 3 other antibiotics (Penicillin, Tetracycline, and Vancomycin). Again, no zone around each med saturated pad because antibiotics are ineffective.
Then we did an experiment where we had a "spill" and each group had a different disinfectant. We had Hydrogen Peroxide. The Professor had us make a 3x3 inch square and he spread an organism into it. We separated the square into 4 quadrants and sprayed hydrogen peroxide into the whole square and quickly swabbed the first quadrant for "0min." Then we swabbed each other quadrant, one after 1 min, 5 min, then 10 min to see how effective hydrogen peroxide is at killing bacteria, Here were the results:

0 min
1 min
5 min
10 min.
You can see how most of the bacteria were killed after 10min. Hydrogen Peroxide is usually very effective, and kills 100% of bacteria. The reason there were still organisms after 10 min was because the hydrogen peroxide was expired.